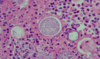

Specific cocci treatments?
Diffuse primary pneumonia and chronic pneumonia
- begin with AMB for diffuse dz. Otherwise, azole therapy.
Disseminated non-meningeal disease, depending on severity
- AMB initially, then azole drug
- AMB plus azole
- Itraconazole or posaconazole alone
Coccidioidal meningitis
- Fluconazole alone
- AMB intrathecal plus fluconazole
- Voriconazole for those who cannot tolerate fluconazole
Organisms most responsible for chromoblastomycosis?
Fonsecaea pedrosoi
Targets for fungal treatment?
Polyenes - amphoterecin

What animals transmit histoplasmosis?
Bats and birds, grows in soil enriched with faeces of bats and birds. Birds are not infected, bats are.
What azoles can be used to treat zygomycetes?
Posiconazole
Isavuconazole
What is an endemic fungi?
Organisms restricted to geographic or climatic environments
Disease forms of paracocci?
Acute/sub acute or juvenile - rapidly progressive (less common)
Chronic or adult - develop over years - long latency period and reactivation
3 spectrum of disease
- Acute
- chronic in immunocompetent (reactivation)
- chronic in immunocompromised (reactivation)
First choice azole for candidiasis both invasive and non invasive?
Fluconazole
(Voriconazole second line)
What is the epidemiology for sporotrichosis?
Peruvian highlands, urban Brazil
Enriched soil and decaying veg matter
Classic men in manual labour
Must have a skin trauma
Rx of cryptococcosis?
Fluconazole
2nd line vori
Classic feature of sporotrichosis?
Follows lymphatics, painful
Which deep fungi do you need to go to an endemic area to contract?
Histoplasmosis, paracocci
Diagnosis of PCM?
Direct microscopy from scrape of lesion, KOH preparation
Round yeast cell with peripheral budding (MM)
Can also do histopathology preparation, antibody detection using ELISA
What is the presentation of extracutaneous sporotrichosis?
VERY RARE
Pulmonary
CNS
What can use anidulafungin to treat?
Fungical activity against Candida; static vs Aspergillus
species; intermediate activity against dimorphic fungi
(Histoplasma, Blastomyces; Coccidioides)
Side effect of posiconazole?
Analogue of itraconazole so very similar (heart failure)
Skin lesions in paracocci?
Predominantly on face
Pleomorphic - papules, vesicles
What is this?

Sporotrichosis
Where do -Azoles work? How?
Cell membrane
Azoles inhibit the synthesis of ergosterol by blocking
demethylation of lanosterol
What are the deep fungal infections?
Histoplasma capsulatum
Cryptococcus neoforman
Paracoccidiodomycosis
Aspergillus fumigateurs
What is the test for cryptococcal?
Culture - india ink
CRAG antigen
DOESN’T stain
Problem of voriconazole comparative to fluconazole?
Visual disturbances
Hepatotoxicity
Skin rash, photosensitivity
Drug interaction
What are the CXR findings of Paracocci?
Unilateral patchy infiltrate. Less common, dense lobar or segmental infiltrate with atelectasis.
Can cause CAVITIES
Hilar and/or
mediastinal adenopathy often present.

Name the diagnosis

Mickey Mouse and ships wheel - paracocci